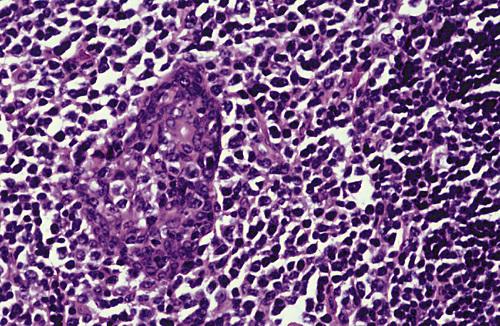
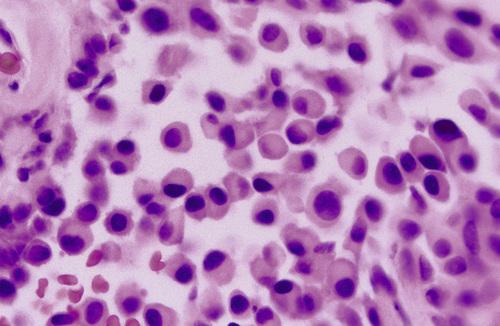
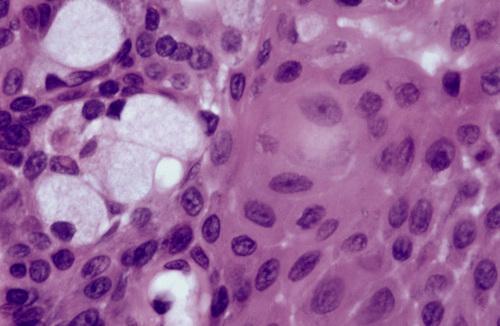

Clinical Features
- more frequent in males than females (2 : 1)
- agenesis of major salivary glands
- normal facial appearance
- severe xerostomia
- dry, leathery tongue
- increase risk for caries
salivary gland aplasia

Dry, leathery tongue and diffuse enamel erosion in a child with absence of the major salivary glands. Some patients also may exhibit absence of lacrimal glands.
salivary gland aplasia
An autosomal dominant disorder caused by mutations in the fibroblast growth factor 10 (FGF10) gene, characterized by aplasia or hypoplasia of the lacrimal and salivary glands, cup-shaped ears, hearing loss, and dental and digital anomalies.
lacrimo-auriculo-dento-digital (LADD) syndrome
What is the treatment and prognosis for salivary gland aplasia?
- saliva substitutes
- sialagogues (e.g. pilocarpine or cevimeline)
- salivary stimulation with sugarless gum or candy
- preventive dental care to avoid xerostomia-related caries
A common lesion of the oral mucosa that results from rupture of a salivary gland duct and spillage of mucin into the surrounding soft tissues.
mucocele
Clinical Features
- dome-shaped mucosal swelling
- 1 or 2 mm to several centimeters in size
- most common in children and young adults
- bluish translucent hue or normal color (if deeper)
- characteristically fluctuant, but some feel firm
- often periodically rupture then recur
- lower lip is by far the most common site
- occur lateral to the midline
Histopathologic Features
- mucin surrounded by a granulation tissue
- numerous foamy histiocytes (macrophages)
- adjacent glands often contain chronic inflammatory cell infiltrate
mucocele

Blue-pigmented nodule on the lower lip. There is often a bluish translucent hue to the swelling, although deeper lesions may be normal in color.
mucocele

Nodule on the posterior buccal mucosa. The reported duration of the lesion can vary from a few days to several years; most patients report several weeks.
mucocele

Exophytic lesion on the anterior ventral tongue from the glands of Blandin-Nuhn. The lower lip is by far the most common site for this type of lesion.
mucocele
Clinical Features
- clinical variant of mucocele
- occurs on soft palate and posterior buccal mucosa
- single or multiple tense vesicles
- measure 1 to 4 mm in diameter
- often burst, leaving shallow, painful ulcers
- associated with lichenoid disorders
superficial mucocele

Vesicle-like lesion on the soft palate. The pathologist must be aware of this lesion and should not mistake it microscopically for a vesiculobullous disorder.
superficial mucocele

Mucin-filled cystlike cavity beneath the mucosal surface. Minor salivary glands are present below and lateral to the spilled mucin.
mucocele

High-power view showing spilled mucin that is associated with granulation tissue containing foamy histiocytes.
mucocele
What is the treatment and prognosis for mucocele?
- short-lived lesions that rupture and heal by themselves
- chronic lesions may require local surgical excision
- adjacent minor salivary glands removed to minimize recurrence
- excised tissue should be submitted to rule out tumor
- prognosis is excellent despite occasional recurrence
A term used for mucoceles that occur in the floor of the mouth, lateral to the midline, arising from the sublingual gland.
ranula (rana means “frog”)
Clinical Features
- blue, dome-shaped, fluctuant swelling
- occur on floor of the mouth, lateral to midline
- arise from the sublingual gland
- most frequent in children and young adults
- may dissect mylohyoid and produce neck swelling ("plunging")
Histopathologic Features
- similar to that of a mucocele
- spilled mucin elicits a granulation tissue response
- typically contains foamy histiocytes
ranula

Blue-pigmented swelling in the left floor of the mouth. Its located lateral to the midline, a feature that may help to distinguish it from a midline dermoid cyst
ranula

Soft swelling in the neck. CT and MRI often exhibit a slight extension of the lesion into the sublingual space, known as a “tail sign.”
plunging ranula
What is the treatment and prognosis for ranula?
- removal of sublingual gland and/or marsupialization
- removal most important in preventing recurrence
An epithelium-lined cavity that arises from salivary gland tissue.
salivary duct cyst
Clinical Features
- usually occur in adults
- arise within either major or minor glands
- most common major gland is parotid
- slowly growing, asymptomatic swelling (major glands)
- minor glands on floor of the mouth, buccal mucosa, and lips
- soft, fluctuant swelling, may appear bluish (minor glands)
- may develop salivary ductal ectasia (“mucus retention cysts”)
Histopathologic Features
- lining of cuboidal, columnar, or atrophic squamous epithelium
- thin or mucoid secretions in the lumen
salivary duct cyst

Nodular swelling overlying Wharton duct. Lesions on the floor of the mouth often arise adjacent to the submandibular duct and sometimes have an amber color.
salivary duct cyst

- Low-power photomicrograph showing a cyst below the mucosal surface.
- High-power view of cystic cavity lined by thin cuboidal epithelium. Adjacent to the cyst is an excretory salivary gland duct lined by columnar epithelium.
salivary duct cyst

This dilated duct is lined by columnar eosinophilic oncocytes that exhibit papillary folds into the ductal lumen. Such lesions may develop secondary to ductal obstruction.
salivary ductal ectasia
What is the treatment and prognosis for salivary duct cyst?
- conservative surgical excision
- lesion should not recur
- sialagogue medications
Calcified structures that develop within the salivary ductal system.
sialolith
Clinical Features
- submandibular ducts (80%)
- glands of upper lip or buccal mucosa
- young and middle-aged adults
- episodic pain or swelling, especially at mealtime
- hard mass palpable beneath mucosa
- radiopaque masses
Histopathologic Features
- round, oval, or cylindrical hard mass
- typically yellow, white or yellow-brown
- concentric laminations surrounding nidus of debris
- squamous, oncocytic, or mucous cell metaplasia
- periductal inflammation
sialolith

Hard mass at the orifice of Wharton duct. The long, tortuous, upward path of this duct and its thicker, mucoid secretions may be responsible for this finding.
sialolith

Radiopaque mass located at the left angle of the mandible. They may be discovered anywhere along the length of the duct or within the gland itself.
sialolith

- Periapical film showing discrete radiopacity superimposed on the body of the mandible. Care must be taken not to confuse this with intrabony pathosis.
- Occlusal radiograph of same patient demonstrating radiopaque mass in Wharton duct.
sialolith

- A mass of a minor gland presenting as a hard nodule in the upper lip.
- A soft tissue radiograph revealed a laminated calcified mass.
sialolith
What is the treatment and prognosis for sialolith?
- gentle massage
- sialagogues
- moist heat
- increased fluid intake
- surgical removal
- shock wave lithotripsy
- sialendoscopy with basket retrieval
Inflammation of the salivary glands.
sialadenitis
Inflammation of the salivary glands (sialadenitis) can arise from various infectious and noninfectious causes. Name at least one cause from each of the following categories:
- viral infection
- bacterial infection
- iatrogenic
- systemic
- mumps
- Staphylococcus aureus
- recent surgery (especially abdominal)
- Sjögren syndrome
Clinical Features
- most common in parotid gland
- bilateral in 10% to 25% of cases
- gland is swollen and painful
- skin is warm and erythematous
- low-grade fever and trismus
- purulent discharge from duct orifice
- obstruction and sialectasia
- “sausaging” sialographic pattern
Histopathologic Features
- inflammatory cell infiltrate
- acinar atrophy and ductal dilatation
- fibrosis may be present ("sclerosing")
sialadenitis

Tender swelling of the submandibular gland. An associated low-grade fever and trismus may be present.
sialadenitis

A purulent exudate can be seen arising from Stensen duct when the parotid gland is massaged.
sialadenitis

Parotid sialogram demonstrating “sausaging” ductal dilatation proximal to an area of obstruction.
sialadenitis

Chronic inflammatory infiltrate with associated acinar atrophy, ductal dilatation, and fibrosis.
chronic sclerosing sialadenitis
The most common inflammatory salivary disorder of children, characterized by recurring non-suppurative parotid swelling, beginning between ages 3 and 6.
juvenile recurrent parotitis
A form of salivary inflammation involving minor salivary glands of the hard or soft palate that presents as a painful nodule covered by erythematous mucosa.
subacute necrotizing sialadenitis
What is the treatment and prognosis for sialadenitis?
- screening panoramic radiograph to check for sialolith
- bacterial culture and sensitivity if purulence is present
- antibiotic therapy, rehydration, surgical drainage (acute)
- antibiotics, analgesics, corticosteroids, sialagogues (chronic)
- sialoendoscopy and ductal irrigation
- surgical removal of the affected gland may be necessary
Clinical Features
- lower lip vermilion, upper lip, and palate
- swelling and eversion of the lower lip
- hypertrophy and inflammation of glands
- inflamed and dilated openings of ducts
- mucopurulent secretions from openings
- middle-aged and older men
Histopathologic Features
- chronic sialadenitis
- ductal dilatation
- mucin accumulation
- oncocytic ductal metaplasia
cheilitis glandularis

Prominent lower lip with inflamed openings of the minor salivary gland ducts. An early squamous cell carcinoma has developed just lateral to the midline.
cheilitis glandularis
What is the treatment and prognosis for cheilitis glandularis?
- vermilionectomy (lip shave) produces a satisfactory result
- associated with development of squamous cell carcinoma
- solar radiation likely responsible for malignant degeneration
Clinical Features
- excessive salivation
- drooling and choking
- macerated sores around mouth
- associated with
- gastroesophageal reflux
- rabies
- heavy-metal poisoning
- certain medications
- intellectual disability
- neurologic disorders
sialorrhea
Short episodes of excessive salivation lasting from 2 to 5 minutes associated with a prodrome of nausea or epigastric pain.
idiopathic paroxysmal sialorrhea
What is the treatment and prognosis for sialorrhea?
- if transitory or mild, and no treatment is needed
- anticholinergic medications
- transdermal scopolamine (only over age 10)
- botulinum toxin (duration of action up to 6 months)
- surgery (e.g. gland excision, duct ligation, ductal relocation)
A subjective sensation of a dry mouth; it is frequently, but not always, associated with salivary gland hypofunction.
xerostomia
A number of factors may play a role in the cause of xerostomia. Name at lease one cause from each of the following categories:
- developmental
- metabolic
- iatrogenic
- systemic
- local
- salivary gland aplasia
- vomiting, diarrhea, impaired fluid intake
- medications, radiation, chemotherapy
- Sjögren syndrome, diabetes mellitus
- smoking, mouth breathing
More than 500 drugs have been reported to produce xerostomia as a side effect, including 63% of the 200 most frequently prescribed medications. Name at least one drug in each of the following classes that can cause xerostomia:
- antihistamines
- decongestants
- antidepressants
- antipsychotics
- anxiolytics
- antihypertensives
- anticholinergics
- diphenhydramine
- loratadine
- fluoxetine
- haloperidol
- diazepam
- metoprolol
- atropine
Clinical Features
- reduction in salivary secretions
- foamy, thick, or “ropey” saliva
- dry, "sticky" mucosa
- fissured tongue with atrophic papillae
- difficulty chewing and swallowing
- increased prevalence of oral candidiasis
- more prone to dental decay
- associated with radiation therapy
xerostomia
What is the treatment and prognosis for xerostomia?
- treatment is difficult and often unsatisfactory
- artificial salivas
- sugarless candy to stimulate salivary flow
- lactoperoxidase, lysozyme, and lactoferrin (e.g. Biotene)
- discontinuation or dose modification if drug-related
- sialagogues (pilocarpine and cevimeline)
- frequent dental visits
- daily fluoride application and chlorhexidine mouth rinses
Both pilocarpine, a parasympathomimetic agonist, and cevimeline, a cholinergic agonist, can be used as sialagogues except in patients with what condition?
narrow-angle glaucoma
Clinical Features
- middle-aged and older adults (mean age, 60 years)
- affects the pancreas and head and neck region
- unilateral or bilateral submandibular gland swelling
- from 1.5 cm to 5 cm in diameter
- pancreatitis and hepatic failure
- abdominal aortitis with aneurysm formation
- inflammatory pseudotumors of the kidney
- thyroid inflammation and lymphadenopathy
Histopathologic Features
- chronic sclerosing sialadenitis
- heavy lymphoplasmacytic infiltrate
- hyperplastic lymphoid follicles
- acinar atrophy
- interlobular fibrosis (storiform pattern)
- obliterative phlebitis (highlighted with elastic stain)
- overall pattern termed "Küttner tumor"
IgG4-related disease
What is the treatment and prognosis for IgG4-related disease?
- immediate, aggressive treatment with systemic corticosteroids
- glucocorticoid-sparing agents (e.g. azathioprine, methotrexate)
- most show rapid response and have a favorable prognosis
A chronic, systemic autoimmune disorder that principally involves the salivary and lacrimal glands, resulting in xerostomia (dry mouth) and xerophthalmia (dry eyes).
Sjögren syndrome
Sicca syndrome alone with no other autoimmune disorder is present.
primary Sjögren syndrome
Sicca syndrome in addition to another associated autoimmune disease.
secondary Sjögren syndrome
Clinical Features
- most common in middle-aged females
- xerostomia with "foamy" saliva
- fissured tongue and atrophic papillae
- red, tender oral mucosa
- secondary candidiasis and angular cheilitis
- dental decay, especially cervically
- enlargement of major salivary glands
- “fruit-laden, branchless tree” sialographic pattern
- keratoconjunctivitis sicca
Laboratory Values
- high ESR
- high IgG
- positive RF
- positive ANA (75% to 85%)
- positive anti-SS-A (50% to 76%)
- positive anti-SS-B (30% to 60%)
Histopathological Features
- lymphocytic infiltration of salivary glands
- destruction of acinar units
- hyperplastic ductal and myoepithelial cells
- groups of cells ("epimyoepithelial islands")
Sjögren syndrome
When the condition is associated with another connective tissue disease, it is called secondary Sjögren syndrome. What is the most common associated disorder?
rheumatoid arthritis
The reduced tear production by the lacrimal glands and pathologic effect on the epithelial cells of the ocular surface seen in Sjögren syndrome.
keratoconjunctivitis sicca
What is a focus score?
A calculation of the number of inflammatory aggregates per 4-mm2 of salivary gland tissue used in the diagnosis of Sjögren syndrome.

Dry and fissured tongue. The patient also complained of difficulty in swallowing, altered taste, and a scratchy, gritty sensation in the eye.
Sjögren syndrome

Benign lymphoepithelial lesion of the parotid gland. A parotid sialogram revealed a “fruit-laden, branchless tree” pattern.
Sjögren syndrome

Parotid sialogram demonstrating demonstrating atrophy and punctate sialectasia producing a “fruit-laden, branchless tree” pattern.
Sjögren syndrome
Lymphocytic infiltrate of the parotid gland with an associated epimyoepithelial island. Lymphocytic infiltration of the minor glands also occurs, although epimyoepithelial islands are rarely seen in this location.
Sjögren syndrome
Labial gland biopsy showing multiple lymphocytic foci. A focus score ≥ 1 (i.e. one or more foci of 50 or more cells per 4-mm2 area of glandular tissue) is considered supportive of the diagnosis of this disease.
Sjögren syndrome
What is the treatment and prognosis for Sjögren syndrome?
- treatment is mostly supportive
- artificial tears and artificial saliva
- sugarless candy or gum for salivary stimulation
- lactoperoxidase, lysozyme, and lactoferrin (e.g. Biotene)
- sialagogues (e.g. pilocarpine or cevimeline)
- daily fluoride applications
- antifungal therapy for secondary candidiasis
- lifetime risk for lymphoma of 5% to 15% (20 times incresed)
An unusual noninflammatory disorder characterized by salivary gland enlargement, particularly involving the parotid glands.
sialadenosis
Sialadenosis is frequently associated with an underlying systemic problem. Name at least one possible cause from each of the following categories:
- endocrine
- nutritional
- neurogenic
- diabetes, acromegaly, hypothyroidism
- malnutrition, alcoholism, bulimia
- antihypertensive, psychotropic, or sympathomimetic drugs
Clinical Features
- slowly swelling of parotid glands
- may or may not be painful
- usually bilateral
- decreased salivary secretion
- “leafless tree” sialographic pattern
Histopathologic Features
- hypertrophy of acinar cells
- nuclei displaced to cell base
- cytoplasm engorged with zymogen granules
- acinar atrophy and fatty infiltration
- no inflammation
sialadenosis
Enlargement of the parotid and submandibular glands secondary to alcoholism. Sialography demonstrates a “leafless tree” pattern.
sialadenosis
What is the treatment and prognosis for sialadenosis?
- control underlying cause (e.g. hypothyroidism, alcoholism)
- partial parotidectomy can be performed
- pilocarpine is reportedly beneficial in reducing enlargement
Clinical Features
- localized swelling of minor salivary glands
- mimics neoplasm
- hard or soft palate
- fourth to sixth decades of life
- sessile, painless masses
- normal color, or red or bluish
Histopathologic Features
- lobules of normal-appearing mucous acini
- glands situated close to mucosal surface
- occasional chronic inflammation
adenomatoid hyperplasia
What is the treatment and prognosis for adenomatoid hyperplasia?
- biopsy is necessary to establish diagnosis
- once diagnosed, no further treatment is indicated
- should not recur
An uncommon, locally destructive inflammatory condition of the salivary glands, thought to result from ischemia of salivary tissue leading to local infarction.
necrotizing sialometaplasia
Clinical Features
- palatal salivary glands
- posterior palate (75%)
- unilateral (two-thirds)
- most often in adult males
- nonulcerated swelling with pain or paresthesia
- necrotic tissue sloughs, leaving craterlike ulcer
- 1 cm to more than 5 cm
- “a part of my palate fell out”
Histopathologic Features
- acinar necrosis in early lesions
- squamous metaplasia of salivary ducts
- preservation of lobular architecture
- liberation of mucin
necrotizing sialometaplasia

Early lesion demonstrating swelling of the posterior lateral hard palate. Within 2 to 3 weeks, necrotic tissue sloughs out, leaving a craterlike ulcer.
necrotizing sialometaplasia

Later-stage lesion showing craterlike defect of the posterior palate. The patient may report that “a part of my palate fell out.”
necrotizing sialometaplasia

Necrotic mucous acini (left) and adjacent ductal squamous metaplasia (right). The overall lobular architecture of the involved glands is still preserved.
necrotizing sialometaplasia
What is the treatment and prognosis for necrotizing sialometaplasia?
- biopsy is indicated to rule out malignant disease
- once diagnosed, no specific treatment is necessary
- resolves on its own, with healing time of 5 to 6 weeks
What is the most common site for salivary gland tumors?
- parotid gland
- submandibular gland
- sublingual gland
- minor glands

A. parotid gland
The most common site for salivary gland tumors is the parotid gland, accounting for 61% to 80% of all cases.
What is the most common type of parotid gland tumor?
- Warthin tumor
- mucoepidermoid carcinoma
- pleomorphic adenoma
- acinic cell carcinoma

C. pleomorphic adenoma
The pleomorphic adenoma is overwhelmingly the most common tumor, representing 50% to 77% of all cases in the parotid gland. Warthin tumors are also fairly common, accounting for 5% to 22% of cases.
What is the most common malignant tumor of the submandibular gland?
- mucoepidermoid carcinoma
- acinic cell carcinoma
- adenoid cystic carcinoma
- squamous cell carcinoma

D. adenoid cystic carcinoma
Only 8% to 11% of salivary tumors occur in the submandibular gland, but frequency of malignancy is much greater than for the parotid, ranging from 26% to 45%.
What is the most likely site for a malignant salivary gland tumor?
- parotid gland
- submandibular gland
- sublingual gland
- minor glands
C. sublingual gland
Tumors of the sublingual gland are rare, comprising no more than 1% of all salivary neoplasms. However, 70% to 95% of sublingual tumors are malignant.
What is the most common malignant tumor of the minor salivary glands?
- mucoepidermoid carcinoma
- acinic cell carcinoma
- adenoid cystic carcinoma
- squamous cell carcinoma

A. mucoepidermoid carcinoma
Mucoepidermoid carcinoma is the most frequent malignancy of minor gland origin, comprising 13% to 23% of all tumors.
Excluding rare sublingual tumors, it can be stated that the ___ the gland is, the ___ is the likelihood of malignancy for a salivary gland tumor.
- larger, greater
- larger, lesser
- smaller, lesser
- smaller, greater
B and D
The smaller (larger) the gland is, the greater (lesser) is the likelihood of malignancy for a salivary gland tumor.
What is the most frequent site for a minor salivary gland tumor?
- lip
- buccal mucosa
- palate
- floor of the mouth
- tongue
- retromolar

C. palate
Most of these occur on the posterior lateral hard or soft palate, which have the greatest concentration of glands.
Which is a more common location for minor salivary gland tumors, the upper lip or the lower lip?

Labial tumors are significantly more common in the upper lip, which accounts for 74% to 87% of all lip tumors.
Which are the three most likely sites for a malignant minor salivary gland tumor?
- lip
- floor of the mouth
- tongue
- palate
- buccal mucosa
- retromolar
B, C, and F
Up to 95% of retromolar tumors are malignant because of a predominance of mucoepidermoid carcinomas; most tumors in the floor of the mouth and tongue are also malignant.
Clinical Features
- young and middle-aged adults (30 to 60 years)
- slight female predilection
- superficial lobe of parotid gland
- painless, slowly growing, firm mass
- minor glands of the palate
- smooth-surfaced, dome-shaped masses
Histopthologic Features
- well-circumscribed, encapsulated tumor
- mixture of glandular epithelium and myoepithelial cells
- myoepithelial cells resembing plasma cells ("plasmacytoid")
- accumulation of mucoid material
- vacuolar degeneration produces chondroid appearance
- areas of an eosinophilic, hyalinized change
pleomorphic adenoma

Small, firm nodule located below the left ear in the parotid gland, which represents the most common salivary neoplasm.
pleomorphic adenoma

Slowly growing tumor of the parotid gland. The patient may be aware of the tumor for many months or years before seeking a diagnosis.
pleomorphic adenoma

Tumor of the submandibular gland. The most common location for this mixed tumor is the superficial lobe of the parotid gland.
pleomorphic adenoma

- Large tumor from the deep lobe of the parotid gland, which has resulted in a firm mass of the lateral soft palate.
- Contrast-enhanced axial magnetic resonance image (MRI) of a tumor of the deep lobe of the parotid gland.
pleomorphic adenoma

Firm mass of the hard palate lateral to the midline. Palatal tumors almost always are found on the posterior lateral aspect of the palate, presenting as smooth-surfaced, dome-shaped masses.
pleomorphic adenoma

Tumor of the pterygomandibular area. If the tumor is traumatized, then secondary ulceration may occur.
pleomorphic adenoma

Low-power view showing a well-circumscribed, encapsulated tumor mass. Even at this power, the mixture of glandular epithelium and myoepithelial cells is evident.
pleomorphic adenoma
These plasmacytoid myoepithelial cells are rounded and demonstrate an eccentric nucleus and eosinophilic hyalinized cytoplasm, thus resembling plasma cells.
pleomorphic adenoma

Ductal structures (left) with associated myxomatous background (right) produced from extensive accumulation of mucoid material between myoepithelial tumor cells.
pleomorphic adenoma

Chondroid material (right) with adjacent ductal epithelium and myoepithelial cells. The chondroid appearance results from vacuolar degeneration of tumor cells.
pleomorphic adenoma

Many of the ducts and myoepithelial cells are surrounded by a hyalinized, eosinophilic background alteration. At times, fat or osteoid also is seen.
pleomorphic adenoma
What is the treatment and prognosis for pleomorphic adenoma?
- best treated by surgical excision
- with adequate surgery, prognosis is excellent (95% cure rate)
- malignant degeneration is a potential complication (3% to 4%)
A benign salivary gland tumor composed of large epithelial cells known as oncocytes.
oncocytoma
Clinical Features
- peak prevalence in the sixth to eighth decades
- primarily major salivary glands, especially parotid (85% to 90%)
- firm, slowly growing, painless mass
- rarely exceeds 4 cm in diameter
- occurs bilaterally on occasion
Histopathologic Features
- well-circumscribed tumor
- sheets of large polyhedral cells (oncocytes)
- abundant granular, eosinophilic cytoplasm
- centrally located nuclei of variable appearance
- sparce stroma of thin fibrovascular septa
- overabundance of mitochondria
oncocytoma

Sheet of large, eosinophilic oncocytes. The granularity of the cells corresponds to an overabundance of mitochondria, which can be demonstrated by electron microscopy.
oncocytoma
What is the treatment and prognosis for oncocytoma?
- best treated by surgical excision
- prognosis after removal is good, with a low recurrence rate
- rare malignant oncocytomas have been reported
The proliferation and the accumulation of oncocytes within salivary gland tissue.
oncocytosis
Clinical Features
- primarily in the parotid gland
- multifocal, nodular proliferation of oncocytes
- occurs most frequently in older adults
Histopathologic Features
- focal nodular collections of oncocytes
- granular, eosinophilic cytoplasm from proliferation of mitochondria
- clear cytoplasm from accumulation of glycogen
oncocytosis

Multifocal collections of clear oncocytes (arrows) in the parotid gland. These cells have clear cytoplasm from the accumulation of glycogen.
oncocytosis
What is the treatment and prognosis for oncocytosis?
- it is a benign condition, often only an incidental finding
- no treatment is necessary, and the prognosis is excellent
Clinical Features
- slowly growing, painless, nodular mass
- occurs almost exclusively in parotid gland
- firm or fluctuant to palpation
- unique tendency to occur bilaterally (5% to 17%)
- peak prevalence in the sixth and seventh decades
- frequency much lower in blacks than in whites
- decided male predilection
- associated with cigarette smoking
Histopathologic Features
- one of the most distinctive histopathologic patterns
- mixture of ductal epithelium and lymphoid stroma
- uniform rows of cells surrounding cystic spaces
- abundant, finely granular eosinophilic cytoplasm
- inner layer of tall columnar cells with hyperchromatic nuclei
- outer layer of cuboidal or polygonal cells with vesicular nuclei
- multiple papillary infoldings protruding into cystic spaces
Warthin tumor

Mass in the tail of the parotid gland. This benign neoplasm occurs almost exclusively in the parotid gland and has a tendancy to occur bilaterally.
Warthin tumor

Low-power view showing a papillary cystic tumor with a lymphoid stroma. The epithelium is oncocytic, forming uniform rows of cells surrounding cystic spaces.
Warthin tumor

High-power view of epithelial lining showing double row of oncocytes with adjacent lymphoid stroma. The inner luminal layer consists of tall columnar cells with centrally placed, palisaded, and slightly hyperchromatic nuclei. Beneath this is a second layer of cuboidal or polygonal cells with more vesicular nuclei.
Warthin tumor
What is the treatment and prognosis for Warthin tumor?
- surgical removal is the treatment of choice
- following surgery, a 2% to 6% recurrence rate has been reported
- malignancy has been reported but is exceedingly rare
An uncommon tumor that occurs almost exclusively in minor salivary glands, which was also called monomorphic adenoma due to its its uniform microscopic pattern.
canalicular adenoma
Clinical Features
- striking predilection for upper lip (75%)
- buccal mucosa is second most common
- peak prevalence in seventh decade of life
- definite female predominance (1.8:1)
- slowly growing, painless mass
- ranges from several millimeters to 2 cm
- firm or somewhat fluctuant to palpation
- overlying mucosa may be normal in color or bluish
Histopathologic Features
- monomorphic microscopic pattern
- single-layered cords of columnar or cuboidal epithelial cells
- deeply basophilic nuclei
- adjacent rows of cells may result in a bilayered appearance
- cells enclose ductal structures or larger cystic spaces
- often surrounded by a thin, fibrous capsule
canalicular adenoma

Mass in the upper lip. The overlying mucosa may be normal in color or bluish and can be mistaken for a mucocele. However, this tumor shows a striking predilection for the upper lip, and mucoceles of the upper lip are rare.
canalicular adenoma

Uniform columnar cells forming canal-like ductal structures. The microscopic pattern of this tumor is monomorphic in nature.
canalicular adenoma
What is the treatment and prognosis for canalicular adenoma?
- best treated by local surgical excision
- recurrence is uncommon
Clinical Features
- primarily a tumor of the parotid gland (75%)
- minor glands second most common
- peak prevalence in the seventh decade of life
- more common in females than males (2:1)
- slowly growing, freely movable mass
- less than 3 cm in diameter
Histopathologic Features
- usually encapsulated or well circumscribed
- most
common subtype is the solid variant
- islands and cords of epithelial cells
- small amount of fibrous stroma
- central cells form eddies or keratin pearls
- trabecular subtype demonstrates cordlike epithelial strands
- membranous subtype exhibits islands in a "jigsaw" pattern
basal cell adenoma

Parotid tumor showing cords of basaloid cells arranged in a trabecular pattern. This subtype is characterized by the formation of small, round, ductlike structures.
basal cell adenoma
A hereditary form of basal cell adenoma which often occurs in combination with skin appendage tumors, such as dermal cylindromas and trichoepitheliomas.
membranous basal cell adenoma
What is the treatment and prognosis for basal cell adenoma?
- treatment consists of complete surgical removal
- recurrence is rare, except for membranous subtype (25% to 37%)
- malignant degeneration is rare but possible
Clinical Features
- most arise from minor salivary glands, especially on palate
- usually is seen in older adults
- more common in males than females (1.5 : 1.0)
- exophytic, papillary surface growth
Histopathologic Features
- multiple exophytic papillary projections
- covered by stratified squamous epithelium
- ductal lumina lined by a double-rowed layer of cells
- luminal layer of tall columnar cells
- basilar layer of smaller cuboidal cells
sialadenoma papilliferum

Exophytic papillary mass on the palate. The tumor commonly arises from the minor salivary glands and appears clinically similar to the common squamous papilloma.
sialadenoma papilliferum

- Low-power view showing a papillary surface tumor with associated ductal structures in the superficial lamina propria.
- High-power view of cystic areas lined by papillary, oncocytic epithelium.
sialadenoma papilliferum
Clinical Features
- minor salivary glands of adults
- lower lip and mandibular vestibule
- asymptomatic nodule
- may show a pit or indentation
Histopathologic Features
- proliferation of squamoid epithelium
- multiple thick, bulbous papillary projections
- cuboidal or columnar cells lining projections
- scattered mucus-producing cells
inverted ductal papilloma

Exophytic mass with central papillary projections on the lower labial mucosa. This rare tumor has been described only in the minor salivary glands of adults.
inverted ductal papilloma

Papillary intraductal proliferation located beneath the mucosal surface. Higher-power view shows both squamous cells and mucous cells (inset).
inverted ductal papilloma
What is the treatment and prognosis for ductal papillomas (sialadenoma papilliferum, intraductal papilloma, or inverted ductal papilloma)?
- best treated by conservative surgical excision
- recurrence is rare
What is the most common salivary gland malignancy?
mucoepidermoid carcinoma
Clinical Features
- occurs in second to seventh decades of life
- most common in the parotid gland
- appears as an asymptomatic swelling
- pain or facial nerve palsy may develop
- minor glands second most common site
- sometimes fluctuant and have blue or red color
Histopathologic Features
- mixture of mucus and epidermoid cells
- mucous contain abundant foamy cytoplasm
- stains positively with mucin stains
- epidermoid cells characterized by squamoid features
- intermediate progenitor cells
- histopathologic grade based on:
- cyst formation (associated with low-grade)
- cytologic atypia (associated with high-grade)
- cell types (mucous cells associated with low-grade)
mucoepidermoid carcinoma

Blue-pigmented mass of the posterior lateral hard palate. The minor glands constitute the second most common site for this malignancy.
mucoepidermoid carcinoma

Mass of the tongue. Although the lower lip, floor of mouth, tongue, and retromolar pad areas are uncommon locations for salivary gland neoplasia, this is the most common salivary tumor in each of these sites.
mucoepidermoid carcinoma

Low-power view of a moderately well-differentiated tumor showing ductal and cystic spaces surrounded by mucous and squamous (epidermoid) cells.
mucoepidermoid carcinoma

This low-grade tumor shows numerous large mucous cells surrounding a cystic space. Higher grade tumors show consist of solid islands of squamous and intermediate cells, demonstrating considerable pleomorphism and mitotic activity.
mucoepidermoid carcinoma
High-power view showing a sheet of squamous epidermoid cells with focal mucus-producing cells (left). A third type of cell—the intermediate cell— is believed to be a progenitor of both the mucous and the epidermoid cells.
mucoepidermoid carcinoma

Clear cell tumor. The typical presentation for this tumor is a mixture of mucus-producing cells and squamous (epidermoid) cells
mucoepidermoid carcinoma

High-power view showing a sheet of pleomorphic squamous epithelial cells intermixed with mucous and intermediate cells. Lower grade tumors show cyst formation, minimal cellular atypia, and a greater proportion of mucous cells.
mucoepidermoid carcinoma
What is the treatment and prognosis for mucoepidermoid carcinoma?
- usually treated by surgical excision
- neck dissection is indicated if clinical evidence of metastasis
- low-grade tumors have a good prognosis (90% to 98% cured)
- high-grade tumors is more guarded (30% to 54% survive)
- submandibular tumors have poorer outlook than parotid tumors
Clinical Features
- intrabony salivary tumor
- most common in middle-aged adults
- slight female predilection
- more common in the mandible (molar-ramus area)
- presenting symptom is cortical swelling
- unilocular or multilocular radiolucency
- well-defined borders
Histopathologic Features
- similar to mucoepidermoid carcinoma
intraosseous mucoepidermoid carcinoma

Multilocular lesion of the posterior mandible. The most frequent presenting symptom is cortical swelling, although some lesions may be discovered incidentally.
intraosseous mucoepidermoid carcinoma
What is the treatment and prognosis for intraosseous mucoepidermoid carcinoma?
- radical surgical resection preferred over conservative
- adjunctive radiation therapy also sometimes is used
- recurrence rat of 40% (conservative) or 13% (radical)
- metastasis has been reported in about 12% of cases
- around 10% die, usually as a result of local recurrence
Clinical Features
- 85% to 90% occur in parotid gland
- even prevalence from second to the seventh decades
- appears as a slowly growing mass
- may be otherwise asymptomatic
- pain or tenderness sometimes is reported
- facial nerve paralysis is an infrequent but ominous sign
Histopathologic Features
- highly variable microscopic appearance
- well circumscribed, sometimes appearing encapsulated
- cells with features characteristic of serous acinar cells
- abundant granular basophilic cytoplasm
- round, darkly stained eccentric nucleus
- pattern resembling normal parotid gland tissue (solid type)
- small cystic spaces containing mucinous material (microcystic type)
- large cystic areas with papillary projections (papillary-cystic type)
- appearance similar to thyroid tissue (follicular type)
acinic cell carcinoma

Large, firm mass of the right parotid gland. Almost all of these tumors occur in the parotid, because this is the largest gland and composed entirely of serous elements.
acinic cell carcinoma

Parotid tumor demonstrating sheet of granular, basophilic serous acinar cells. The most characteristic cell is one with features of the serous acinar cell, with abundant granular basophilic cytoplasm and a round, darkly stained eccentric nucleus.
acinic cell carcinoma

High-power view of serous cells with basophilic, granular cytoplasm. The most characteristic cell is one with features of the serous acinar cell, with abundant granular basophilic cytoplasm and a round, darkly stained eccentric nucleus.
acinic cell carcinoma
What is the treatment and prognosis for acinic cell carcinoma?
- parotid tumors treated by lobectomy or total parotidectomy
- minor gland tumors are treated with surgical excision
- adjunctive radiation therapy may be considered
- one of
the better prognoses of any malignant salivary gland tumors
- 10% to 20% of patients have recurrences locally
- metastases develop in 8% to 11% of patients
- 10% of patients will die of their disease
A newly recognized salivary gland malignancy with histopathologic and molecular features that are similar to secretory carcinoma of the breast.
mammary analogue secretory carcinoma
Clinical Features
- most common in parotid salivary gland (58%)
- less frequent in minor (31%) and submandibular (9%) glands
- mean age is 47 years
- slightly more often in males than in females
- slowly growing, painless mass
Histopathologic Features
- similar to secretory carcinoma of the breast
- tumor cells exhibit bland, vesicular nuclei
- slightly granular or vacuolated cytoplasm
- arranged in solid, tubular, microcystic, or macrocystic structures
- large cystic spaces with papillary infoldings (“hobnail” appearance)
mammary analogue secretory carcinoma

Bluish swelling of the anterior buccal mucosa, which could be mistaken clinically for a mucocele. Histopathologic examination revealed microscopic features similar to those of secretory carcinoma of the breast.
mammary analogue secretory carcinoma

Medium-power view showing papillary-cystic spaces and small solid islands. Larger cystic spaces may exhibit papillary infolding of tumor cells with a “hobnail” appearance.
mammary analogue secretory carcinoma
What is the treatment and prognosis for mammary analogue secretory carcinoma?
- low-grade malignancy with favorable prognosis
- local recurrence and metastases have been documented
- treatment is surgical resection, sometimes with adjuvant radiation
Malignant mixed tumors represent malignant counterparts to the benign mixed tumor or pleomorphic adenoma. What are the three malignant mixed tumors?
- carcinoma ex pleomorphic adenoma
- carcinosarcoma
- metastasizing mixed tumor
Clinical Features
- peak prevalence in sixth to eighth decades
- mostly in major glands (80%), primarily the parotid
- two-thirds of minor salivary gland cases occur on the palate
- many cases present as a painless mass
Histopathologic Features
- areas of typical benign pleomorphic adenoma
- areas of malignant epithelial degeneration
- cellular pleomorphism and abnormal mitotic activity
- invasive (malignant cells penetrating >1.5 mm)
- minimally invasive (invasion ≤1.5 mm)
- noninvasive (malignant focus in encapsuled tumor)
carcinoma ex pleomorphic adenoma

Mass of the parotid gland. Although pain or recent rapid growth is not unusual, many cases present as a painless mass that is indistinguishable from a benign tumor, despite this being the most common malignant mixed tumor.
carcinoma ex pleomorphic adenoma

Granular exophytic and ulcerated mass filling the vault of the palate. Histopathologic examination shows areas of typical benign pleomorphic adenoma with areas of malignant degeneration of the epithelial component.
carcinoma ex pleomorphic adenoma

- A, Medium-power view of the benign portion of the tumor showing sheets of plasmacytoid myoepithelial cells within a myxoid background.
- Malignant portion of the tumor showing epithelial cells with pleomorphic nuclei.
carcinoma ex pleomorphic adenoma
What is the treatment and prognosis for carcinoma ex pleomorphic adenoma
- best treated by wide excision
- possibly lymph node dissection and adjunctive radiation therapy
- prognosis is
guarded
- 5-year survival rate ranges from 25% to 65%
- survival drops to 10% to 35% at 15 years
Clinical Features
- 40% to 45% in minor salivary glands (mostly palatal)
- most common in middle-aged adults
- more common in females than males (1.4:1)
- slowly growing, painful mass
- constant, low-grade, dull ache of increasing intensity
- can be smooth surfaced or ulcerated
- radiographic evidence of bone destruction
Histopathologic Features
- mixture of myoepithelial cells and ductal cells
- islands of basaloid epithelial cells with cystlike spaces (cribriform pattern)
- multiple ducts or tubules within a hyalinized stroma (tubular pattern)
- islands or sheets of cells without duct or cyst formation (solid variant)
- tends to show perineural invasion
adenoid cystic carcinoma

Painful mass of the hard palate and maxillary alveolar ridge. Patients often complain of a constant, low-grade, dull ache, which gradually increases in intensity.
adenoid cystic carcinoma

Computed tomography (CT) scan of this massive palatal tumor shows extensive destruction of the hard palate with extension of the tumor into the nasal cavity and both maxillary sinuses.
adenoid cystic carcinoma

Islands of hyperchromatic cells forming cribriform and tubular structures. Inset shows a high-power view of a small cribriform island. The cribriform pattern is the most classic appearance, characterized cystlike spaces resembling Swiss cheese.
adenoid cystic carcinoma

The tumor cells are surrounded by hyalinized material. In the tubular pattern, the tumor cells are similar but occur as multiple small ducts or tubules within a hyalinized stroma.
adenoid cystic carcinoma

Perineural invasion. This is a highly characteristic feature of this tumor, probably corresponding to the common clinical finding of pain in these patients.
adenoid cystic carcinoma
What is the treatment and prognosis for adenoid cystic carcinoma?
- surgical resection is usually the treatment of choice
- adjuvant radiation therapy may slightly improve patient survival
- prone to local recurrence and eventual distant metastasis
- 5-year survival 77% to 82%, 10-year 60% to 68%, 20-year 35% to 52%
- better survival of (a) females, (b) younger patients, (c) localized disease
- metastases (35%) most frequent to (1) lungs, (2) bone, and (3) brain
Clinical Features
- almost exclusive to minor glands
- peak in sixth to eighth decades
- two-thirds occur in females
- painless, slow growing mass
- may erode underlying bone
Histopathologic Features
- tumor cells with deceptively uniform appearance
- polygonal in shape, with indistinct cell borders
- pale to eosinophilic cytoplasm
- nuclei may be round, ovoid, or spindled
- cells can exhibit different growth patterns ("polymorphous")
- solid pattern or cords, ducts, or larger cystic spaces
- peripheral cells are usually infiltrative ("single file" invasion)
- perineural invasion (mistaken for adenoid cystic carcinoma)
polymorphous low-grade adenocarcinoma

Slow-growing, firm mass of the right posterior lateral hard palate. This tumor occurs almost exclusively in minor salivary glands, and may be mistaken for adenoid cystic carcinoma, however, it is usually painless.
polymorphous low-grade adenocarcinoma

This medium-power view shows a cribriform arrangement of uniform tumor cells with pale-staining nuclei, resembling adenoid cystic carcinoma.
polymorphous low-grade adenocarcinoma

Pale-staining cells that infiltrate as single-file cords. Extension into underlying bone or skeletal muscle may be observed.
polymorphous low-grade adenocarcinoma

Perineural invasion. This may be cause the tumor to be mistaken for adenoid cystic carcinoma, however, distinction between these tumors is important because of their vastly differing prognoses.
polymorphous low-grade adenocarcinoma
What is the treatment and prognosis for polymorphous low-grade adenocarcinoma?
- best treated by wide surgical excision
- distant metastasis is rare
- recurrent rate reported to be 9% to 29%
In spite of the wide variety of salivary gland malignancies that have been specifically identified and categorized, some tumors still defy the existing classification schemes. What are these designated as?
salivary adenocarcinomas, not otherwise specified (NOS)
Clinical Features
- represent such a diverse group of neoplasms
- most common in the parotid gland
- asymptomatic masses or may cause pain
- microscopic appearance is highly variable
salivary adenocarcinoma

“Clear cell” adenocarcinoma of the submandibular gland. As these tumors are studied more, it should be possible to classify some of them into separate, specific categories and allow more definitive analyses of their clinical and microscopic features.
salivary adenocarcinoma

Mass of the posterior lateral hard palate. As these tumors are studied more, it should be possible to classify some of them into separate, specific categories and allow more definitive analyses of their clinical and microscopic features.
salivary adenocarcinoma
What is the treatment and prognosis for salivary adenocarcinoma?
- difficult to predict the prognosis
- early-stage, well-differentiated tumors have a better outcome
- 10-year survival rate parotid tumors ranges from 26% to 55%
- 10-year survival rate of 76% for intraoral tumors